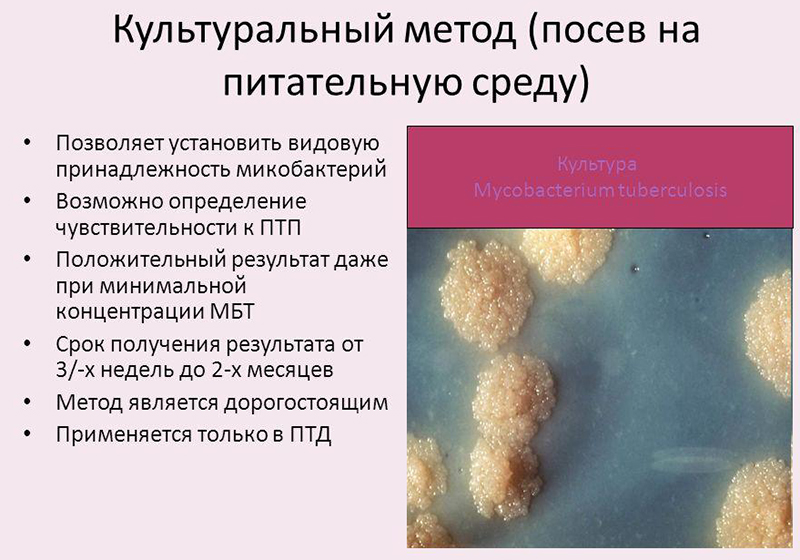
Анализ культулярный для выявления пиелонефрита Анализ культулярный

Своевременное определение симптоматики и постановка диагноза пиелонефрит – это залог того, что будет составлен правильный курс лечения, и его эффективность в кратчайшие сроки возымеет действие над болезнью. Стоит помнить, что пиелонефрит является воспалением в области почек и имеет, в большинстве случаев, бактериальное происхождение. Поэтому любое промедление, при возникающей симптоматике, может отозваться тяжелыми последствиями.
Какие существуют методы диагностики при пиелонефрите
Пиелонефрит, а точнее диагностика этого заболевания, имеет разносторонний подход.
Врачи подчеркивают важность комплексного подхода к диагностике пиелонефрита. Первоначально необходимо провести тщательный сбор анамнеза, включая информацию о симптомах, таких как боль в пояснице, лихорадка и частое мочеиспускание. Физикальное обследование также играет ключевую роль, позволяя выявить болезненность в области почек. Лабораторные исследования, включая общий анализ мочи и бактериологическое посев, помогают определить наличие инфекции и ее возбудителя. УЗИ почек может быть рекомендовано для оценки состояния органов и выявления возможных осложнений. Врачи акцентируют внимание на необходимости ранней диагностики, так как это способствует более эффективному лечению и снижает риск хронических форм заболевания.
https://youtube.com/watch?v=Ojrx0YldzxY
Анализ культулярный
Обычный анализ мочи будет рассмотрен более объемно и детально. Но есть также бактериальный посев мочи, где исследование образца происходит на протяжении определенного количества времени и под воздействием питательной среды. Диагностируется состояние патогенной флоры по характеру окраски жидкости.
Если, к примеру, прорастает определённая колония, а именно палочки синегнойной, то этому будет соответствовать сине-зеленый цвет самой среды. И это характеризует ее активное внедрение и провоцирование пиелонефрита. Недостаток методики заключается в том, что 100 % результат получить невозможно, так как возбудители могут попасть в тестовый образец случайно. Но вот в 85 % случаях вероятность точного диагноза гарантировать можно.
Самый главный недостаток этого метода – это долгая протяженность по временной шкале, потому что на выращивание одной колонии микробов уходит примерно неделя. И все это время необходимо тщательно соблюдать санитарные правила. В помещения, где развивается патоген, нельзя допускать посторонних. И такие необходимые боксы есть только в тех медицинских учреждениях, где ведется научная работа.
Серологическое исследование
Еще один вид диагностирования патологии – это исследование под названием серологическое. Таким способом исследуют биоматериалы. Здесь основная задача – это поиск антител, стойких к болезнетворным микроорганизмам. Если в субстанции крови есть антитела к пиогенному стрептококку, и в моче есть сами стептококки, значит, возникновение пиелонефрита можно приписать их участию.
В этом случае немедленно назначаются препараты, способные уничтожить патогены. Чаще всего встречается попадание пиогенного бета-гемолитического стрептококка в почки непосредственно из миндалин после перенесенных скарлатина или ангины. Он вызывает гнойные воспаления в самых разных внутренних органах и, что еще хуже, может спровоцировать аутоиммунную ревматическую реакцию.
Пиелонефрит — это воспаление почек, которое может проявляться различными симптомами. Люди часто отмечают, что основными признаками заболевания являются высокая температура, боли в пояснице и частое мочеиспускание. Многие делятся опытом, что при первых симптомах стоит обратиться к врачу, так как самостоятельная диагностика может быть опасной. Врач обычно назначает анализы мочи и крови, а также ультразвуковое исследование, чтобы подтвердить диагноз. Некоторые пациенты подчеркивают важность своевременного лечения, так как запущенный пиелонефрит может привести к серьезным осложнениям. Важно помнить, что профилактика, включая соблюдение гигиенических норм и поддержание иммунной системы, играет ключевую роль в предотвращении этого заболевания.
https://youtube.com/watch?v=s4nYpDfkVBc
Исследование почек с помощью инструментов
Для более полного спектра анализов, помимо микробиологических и химических, необходимо также визуальное исследование почки. Используя современные методы диагностики, можно с помощью следующих аппаратов увидеть нарушения, нанесенные болезнью:
- ультразвуковое исследование;
- рентген;
- магнитно-резонансный томограф.
Такое рассмотрение больного органа эффективно помогает в установке правильного диагноза.
Как диагностируется пиелонефрит по анализу мочи
Классическое описание пиелонефрита обычно составляется по анализу мочи.
Урина пациентов анализируется следующими методами:
- бактериологический – с помощью микроскопа при воздействии специфических методов собирается информация о качественном составе жидкости. У взрослых людей урина практически стерильна, так как моча обладает антисептическими свойствами. Но если идет процесс воспаления, то их в бактериальном составе мочи так много, что гибнут они не всей колонией;
- химический – есть норма, которая определяет, в каком количестве должны быть белки, углеводы и соли;
- клинический – этот анализ определяет наличие специфических и неспецифических частиц и клеток, образовываемых при воспалительном процессе. Количество фагоцитов, лейкоцитов, ороговевшего эпителия и клеток показывает стадию воспалительного процесса. Также определяется по степени прозрачности мочи воспалительный фактор: чем мутнее урина, тем хуже состояние.
Самый оптимальный метод – это проба мочи трехстаканная. Пациент разделяет дозу урины на три пробы. Таким образом, клиническая картина бактериологической жидкости получается наиболее емкая. Но такую объективную оценку урины и состояния больного наиболее эффективно применять только для взрослых людей, потому что у детей и пожилых людей сложно взять необходимый для исследования объем. Также если в процессе воспалительного процесса пиелонефрита возникла обструкция мочеиспускательного канала, то такую пробу тоже сложно взять.
В девяностых годах прошлого века российские ученые – академик Шабалин и профессор Шатохин разработали новый уникальный метод под наименованием Литос-система, и на данный момент эта альтернативная система диагностики набирает популярность.
Интересна сама суть данной методики тем, что исследуется не жидкостный состав. Капли мочи подвергаются дегидратированию, то есть высушиванию или фасции. За одни сутки происходит медленное выпаривание жидкости и на лабораторном стекле оседает состав, в котором частицы, оставшиеся в сухом твердом остатке, структурированы, и позволяют в короткие сроки рассмотреть их состав. Тем более, что во время выпаривания происходит упрощение работы для персонала лаборатории, так как каждое вещество разбегается по своим, то есть:
- белки к белкам;
- минералы к минералам;
- соли к солям.
Этот процесс авторы увидели в исследованиях геологов, именно так осаливаются горные породы.
Применение дифференциальной диагностики
Острый пиелонефрит сложен в диагностике тем, что симптомы и результаты исследований необходимо четко разложить по своим местам в классификаторе заболеваний. Потому что схожие симптомы могут быть и при туберкулезе почек, и при многих похожих недугах мочеполовой системы.
Когда проходят исследовательские манипуляции с уриной, стоит обращать внимание на следующие моменты:
- гематогенный пиелонефрит не дает осадка в моче в первые три-четыре дня начала течении болезни;
- при острогнойном пиелонефрите могут присутствовать патологические элементы, но также это может быть вызвано каким-либо другим гнойным процессом.
Поэтому дифференциальная диагностика полностью направлена на то, чтобы исключить ошибочную постановку диагноза и заменить натуральную картину, например, малярии или сепсиса – острым пиелонефритом.
Например, геморрагическая лихорадка или почечный синдром – тоже острое вирусное заболевание, и при этом оно поражает и почки, и дает лихорадку. Но если вовремя исследовать предстательную железу и нижние пути мочеточника, то можно с точностью отличить ее от пиелонефрита.
Хроническое течение заболевания можно дифференцировать с почечным амилоидозом или гипертоническим заболеванием или с хроническим гломеролонефритом. Амилоидоз почек можно также спутать с пиелонефритом в латентной форме. Но следует помнить, что при амиоидозе лейкоциты не активны, бактериурий тоже и рентген от нормы не отклоняется.
Поэтому, при скомканной клинической картине, лучше всего, для точной постановки диагноза, сделать биопсию почки.
https://youtube.com/watch?v=HvfGHpAS6_c
Вопрос-ответ
Какие основные симптомы пиелонефрита?
Симптомы пиелонефрита могут включать боль в пояснице, лихорадку, озноб, частое и болезненное мочеиспускание, а также мутную или неприятно пахнущую мочу. В некоторых случаях могут наблюдаться тошнота и рвота.
Как проводится диагностика пиелонефрита?
Диагностика пиелонефрита обычно включает анализы мочи, которые помогают выявить наличие инфекции, а также анализ крови для оценки функции почек. В некоторых случаях могут потребоваться дополнительные исследования, такие как УЗИ почек или компьютерная томография для оценки состояния почек и выявления возможных осложнений.
Каковы возможные причины развития пиелонефрита?
Пиелонефрит может развиться в результате бактериальной инфекции, которая попадает в почки из мочевого пузыря. Факторы риска включают наличие мочевых инфекций, камней в почках, аномалии мочевыводящих путей, а также ослабленный иммунитет. У женщин пиелонефрит чаще встречается из-за анатомических особенностей.
Советы
СОВЕТ №1
Обратите внимание на симптомы. Пиелонефрит может проявляться такими признаками, как боль в пояснице, высокая температура, озноб, частое и болезненное мочеиспускание. Если вы заметили у себя эти симптомы, не откладывайте визит к врачу.
СОВЕТ №2
Пройдите необходимые анализы. Для диагностики пиелонефрита важно сдать анализы мочи и крови. Это поможет врачу определить наличие инфекции и оценить функцию почек. Не забывайте, что результаты анализов могут занять некоторое время, поэтому лучше не откладывать их сдачу.
СОВЕТ №3
Обсудите с врачом возможные причины. Пиелонефрит может быть вызван различными факторами, такими как мочекаменная болезнь, диабет или аномалии мочевыводящих путей. Уточните у специалиста, какие факторы могут быть актуальны для вас, чтобы предотвратить повторное возникновение заболевания.
СОВЕТ №4
Следите за своим состоянием после лечения. Даже после успешного лечения пиелонефрита важно регулярно проходить обследования и следить за состоянием почек. Это поможет выявить возможные рецидивы на ранней стадии и принять меры для их предотвращения.